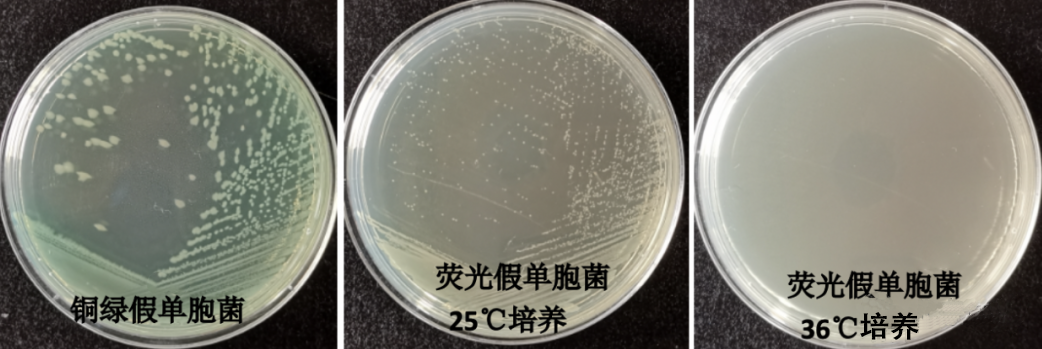

用途:用于铜绿假单胞菌的选择性分离培养(化妆品卫生规范)。
成分(g/L)
|
蛋白胨
|
10.0
|
|
氯化钠
|
5.0
|
|
牛肉膏
|
3.0
|
|
十六烷三甲基溴化铵
|
0.3
|
|
琼脂
|
20.0
|
|
pH值7.5±0.1
|
25℃
|
作用
1.营养成分:铜绿假单胞菌分解蛋白质能力较强,而发酵糖类能力较低,在培养基组分中明胶胰酶水解物和甘油为铜绿假单胞菌的生长提供碳、氮源、维生素和生长因子。
2.无机盐:氯化镁和硫酸钾可以促进绿脓菌素的产生,并维持渗透压。
3.选择性培养的原理:溴化十六烷基三甲铵(cetrimide)作为一种季铵盐阳离子表面活性剂,通过改变细菌细胞的通透性,使细菌发生自溶或引起菌体蛋白质变性沉淀,导致细菌死亡,有较强的抑菌作用。铜绿假单胞菌对溴化十六烷基三甲铵有一定的耐受性,因此,被用于铜绿假单胞菌的选择培养。
4.颜色:铜绿假单胞菌生长过程中会产生两种水溶性色素:黄色的荧光素和绿色的绿脓菌素,所以在溴化十六烷基三甲铵琼脂平板上菌落呈黄绿色。
用法:
称取本品38.3g,煮沸溶解于1000ml蒸馏水中,分装三角瓶,115℃高压灭菌20分钟,备用。
十六烷三甲基溴化铵琼脂上铜绿假单胞菌和荧光铜绿假单胞菌的生长特征:
铜绿假单胞菌36℃培养,生长良好,为黄绿色菌落,
荧光假单胞菌36℃不生长,25℃生长良好,且为淡黄色菌落
十六烷基三甲基溴化铵培养基(化妆品卫生规范)微生物灵敏度试验:
按标签用法制备培养基,接种以下质控菌株,放置36±1℃需氧培养18-24小时。
注:回收率计算时,用TSA琼脂做对照培养基。

相关文章:
十六烷三甲基溴化铵琼脂的使用原理及方法 点击查看


 海博微信公众号
海博微信公众号
 海博天猫旗舰店
海博天猫旗舰店


 海博微信公众号
海博微信公众号
 海博天猫旗舰店
海博天猫旗舰店






